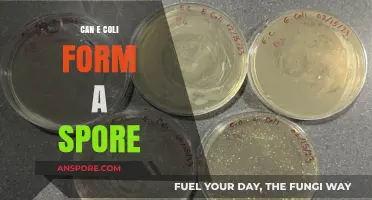
Can E. Coli Form Spores? Unraveling the Bacterial Survival Myth

Darkspore, a sci-fi action role-playing game developed by Maxis and published by Electronic Arts, was released in 2011 as a spin-off of the popular *Spore* franchise. Despite its unique blend of creature customization and cooperative gameplay, the game faced challenges, including server shutdowns and the discontinuation of online features, which significantly impacted its playability. Today, the question of whether *Darkspore* can still be played lingers among fans and curious gamers. While the game is no longer officially supported, dedicated communities have explored workarounds, such as offline mods and private servers, to keep the experience alive. However, these methods often require technical know-how and may not fully replicate the original online experience. As a result, *Darkspore* remains a nostalgic relic for many, with its current playability limited to those willing to navigate its post-shutdown landscape.
| Characteristics | Values |
|---|---|
| Game Status | Officially unplayable due to server shutdown in 2016 |
| Offline Play | Possible via fan-made patches or modifications |
| Availability | No longer available for purchase on official platforms |
| Community Efforts | Fan communities have created workarounds to play offline |
| Multiplayer | Not functional due to server closure |
| Platform | Originally released on PC (Windows) |
| Developer | Maxis (EA) |
| Release Date | April 26, 2011 |
| Genre | Real-time strategy, role-playing |
| Current Playability | Limited to offline modes with community-driven solutions |
Explore related products
What You'll Learn
- Availability of Game Files: Can original or archived files be legally downloaded and installed on modern systems
- Compatibility with OS: Does Dark Spore run on Windows 10/11 or require older operating systems
- SecuROM DRM Issues: Does the game’s DRM prevent installation or playability on current hardware
- Online Multiplayer Status: Are servers still active, or can multiplayer be played via LAN/third-party tools
- Community Patches/Fixes: Do fan-made patches exist to resolve technical issues or enhance gameplay

Availability of Game Files: Can original or archived files be legally downloaded and installed on modern systems?
The legality of downloading and installing original or archived game files for *Darkspore* on modern systems hinges on the game’s current distribution status and copyright laws. As of recent searches, *Darkspore* is no longer available on official platforms like Origin, where it was originally sold. This absence raises questions about whether players can legally obtain the game files through other means, such as archival sites or peer-to-peer networks. While some players have reported success in finding and installing the game from unofficial sources, these actions often exist in a legal gray area. Copyright holders retain exclusive rights to distribute their work, and unauthorized downloads, even for abandoned titles, can still violate intellectual property laws.
For those seeking a legal path, one option is to explore whether the game’s files have been released into the public domain or if the copyright holder has granted permission for redistribution. However, this is rare for commercial titles like *Darkspore*. Another approach is to petition the rights holder (in this case, Electronic Arts) to re-release the game or make it available through archival programs. Initiatives like the Internet Archive’s software collection sometimes include older games, but *Darkspore* is not currently part of such efforts. Without explicit permission or a legal re-release, downloading the game files from unofficial sources remains risky, even if the intent is to preserve access to a discontinued title.
From a technical standpoint, installing *Darkspore* on modern systems is feasible, as the game’s system requirements are well within the capabilities of contemporary hardware. Players have reported success using compatibility modes or tools like Wine for Linux systems. However, the absence of official support means troubleshooting issues like DRM activation or online connectivity falls entirely on the player. This DIY approach underscores the game’s unofficial status and highlights the gap between legal availability and practical playability.
Persuasively, the case for legal archival access to *Darkspore* aligns with broader arguments for digital preservation. Games, like other cultural artifacts, risk being lost to time if not preserved. While copyright laws aim to protect creators, they can inadvertently stifle access to works no longer commercially available. Advocacy for legal frameworks that allow archival distribution of abandoned titles could benefit both players and the cultural record. Until such changes occur, however, players must navigate the legal and ethical complexities of accessing *Darkspore* on their own.
In conclusion, while *Darkspore* can technically be installed and played on modern systems, the legal availability of its original or archived files remains uncertain. Players must weigh the risks of unauthorized downloads against their desire to experience the game. For those committed to legality, the best course of action is to advocate for official re-releases or archival initiatives, ensuring that games like *Darkspore* are preserved for future generations without violating copyright laws.
Exploring the Unique Characteristics of Agaricus Mushroom Spores
You may want to see also

Compatibility with OS: Does Dark Spore run on Windows 10/11 or require older operating systems?
Dark Spore, a real-time strategy game developed by Maxis and published by Electronic Arts, was released in 2011, primarily for Windows XP and Windows 7. Over a decade later, players are still curious about its compatibility with modern operating systems, particularly Windows 10 and Windows 11. The game’s age raises concerns about whether it can run smoothly on newer platforms or if it’s confined to older systems. Understanding its compatibility is crucial for both nostalgic gamers and newcomers alike.
To determine if Dark Spore runs on Windows 10/11, it’s essential to examine its technical requirements and user experiences. The game’s original specifications indicate compatibility with Windows XP and Windows 7, but advancements in operating systems often introduce compatibility issues. However, many users report successful installations on Windows 10 and 11 by employing workarounds such as running the game in compatibility mode or using third-party tools like Wine for Linux-based systems. These solutions suggest that while not natively optimized, Dark Spore can still function on modern OS versions.
One practical tip for running Dark Spore on Windows 10/11 is to enable compatibility mode. Right-click the game’s executable file, select *Properties*, navigate to the *Compatibility* tab, and choose *Windows 7* or *Windows XP (Service Pack 3)*. Additionally, disabling fullscreen optimizations and running the game as an administrator can resolve common launch issues. For users encountering graphical glitches, updating DirectX and installing the latest graphics drivers are recommended steps to ensure smoother gameplay.
Comparatively, Dark Spore’s compatibility challenges are not unique; many older games face similar hurdles on modern systems. However, its reliance on SecuROM DRM complicates matters further, as this software is often flagged by newer operating systems as a security risk. Players may need to temporarily disable antivirus programs or whitelist the game to bypass these restrictions. Despite these obstacles, the game’s enduring appeal motivates players to invest time in troubleshooting, proving that with a bit of effort, Dark Spore remains accessible on Windows 10/11.
In conclusion, while Dark Spore was not designed with Windows 10/11 in mind, it can still be played on these operating systems with some adjustments. By leveraging compatibility settings, updating system components, and addressing DRM-related issues, players can enjoy the game on modern platforms. This adaptability ensures that Dark Spore continues to thrive, bridging the gap between its 2011 origins and today’s gaming environment.
Effective Milky Spore Application: A Step-by-Step Guide for Lawn Grub Control
You may want to see also

SecuROM DRM Issues: Does the game’s DRM prevent installation or playability on current hardware?
SecuROM, a notorious DRM (Digital Rights Management) system, has long been a thorn in the side of gamers, particularly those attempting to revisit older titles like *Darkspore*. Its intrusive nature and compatibility issues with modern hardware raise a critical question: Can games protected by SecuROM still be installed or played today? The answer is complex, hinging on the interplay between outdated DRM mechanisms and contemporary operating systems.
Steps to Tackle SecuROM Issues:
- Verify Compatibility Mode: Before attempting installation, run the game’s setup file in compatibility mode for Windows XP or Windows 7, as SecuROM often struggles with Windows 10 and 11.
- Disable Secure Boot: In your system’s BIOS, temporarily disable Secure Boot, as it can flag SecuROM as a security threat, preventing installation.
- Use Virtual Machines: Install the game in a virtual environment like VMware or VirtualBox, configured to mimic older Windows versions, bypassing direct hardware conflicts.
Cautions to Consider:
SecuROM is known to install low-level drivers that can persist even after uninstallation, potentially causing system instability. Avoid using registry cleaners or force-uninstalling the game, as this may corrupt your system. Additionally, some antivirus software flags SecuROM as malware, so whitelist the game’s executable files during installation.
Comparative Analysis:
Unlike modern DRM solutions like Denuvo, which adapt to current hardware, SecuROM remains static, designed for a bygone era of 32-bit systems and optical drives. While *Darkspore* itself is no longer supported by EA, community patches and workarounds have emerged to mitigate SecuROM’s limitations. For instance, tools like "SecuROM Remover" claim to strip the DRM, though their legality and effectiveness vary.
Practical Tips for Playability:
If installation succeeds, ensure the game runs as an administrator and disable fullscreen optimizations in the executable’s properties. For online features, consider using VPNs or local network play, as SecuROM’s server authentication often fails on modern connections.
While SecuROM’s archaic design poses significant hurdles, *Darkspore* and similar games are not entirely unplayable on current hardware. A combination of technical workarounds, community tools, and patience can breathe new life into these titles, preserving their legacy despite the DRM’s best efforts to render them obsolete.
Are Slime Mold Spores Harmful? Uncovering the Truth and Risks
You may want to see also
Explore related products

Online Multiplayer Status: Are servers still active, or can multiplayer be played via LAN/third-party tools?
Dark Spore's online multiplayer functionality has been a point of contention among players since the game's official servers were shut down. The game, developed by Maxis and published by Electronic Arts, originally featured a robust online multiplayer mode that allowed players to team up and battle against each other or AI opponents. However, with the discontinuation of official support, players have been left to wonder if there are alternative ways to experience the game's multiplayer aspects.
For those seeking to relive the glory days of Dark Spore's online multiplayer, the current landscape presents a mix of challenges and opportunities. While the official servers are no longer active, dedicated communities have emerged, offering solutions to keep the multiplayer experience alive. One such method is through LAN (Local Area Network) play, which enables players to connect with others on the same network. This approach, though limited in scope, provides a viable option for friends or family members who wish to play together in a shared physical space. Setting up a LAN game requires all participants to be on the same network, and while it may not replicate the global reach of the original online mode, it offers a nostalgic and intimate gaming experience.
A more technically involved but potentially rewarding option is the use of third-party tools and mods. Enthusiasts have developed workarounds to enable online multiplayer, often by creating custom servers or utilizing peer-to-peer connections. These solutions typically involve downloading and configuring specific software, such as VPN services or dedicated game mods. For instance, tools like Hamachi or ZeroTier can simulate a LAN environment over the internet, allowing players to connect as if they were on the same local network. While these methods require a bit of technical know-how, they open up the possibility of playing with a wider audience, including strangers who share the same passion for Dark Spore.
It's essential to approach these third-party solutions with caution. Since they are not officially supported, there may be risks involved, such as compatibility issues, security concerns, or the potential for encountering malicious software. Players should research and choose reputable tools, follow community guidelines, and ensure their systems are protected with up-to-date antivirus software. Additionally, joining dedicated forums or Discord servers can provide valuable insights and support from experienced players who have successfully navigated these alternatives.
In conclusion, while Dark Spore's official online multiplayer servers are no longer active, the game's community has ensured that multiplayer experiences are still possible. Whether through LAN play for localized gaming sessions or third-party tools for broader online interactions, players have options to continue enjoying the game's cooperative and competitive modes. Each method comes with its own set of considerations, but with the right approach, Dark Spore's multiplayer legacy can live on, offering both nostalgia and new challenges for dedicated fans.
Do Cones Contain Spores? Unveiling the Truth About Plant Reproduction
You may want to see also

Community Patches/Fixes: Do fan-made patches exist to resolve technical issues or enhance gameplay?
Dark Spore, a real-time strategy game developed by Maxis and published by Electronic Arts, was released in 2011 but was later discontinued, leaving players with limited official support. Despite its abandonment, the game still holds a dedicated fanbase that refuses to let it fade into obscurity. One of the most significant ways this community keeps the game alive is through fan-made patches and fixes, which address technical issues and enhance gameplay. These community-driven efforts are a testament to the resilience and creativity of players who are determined to preserve their favorite titles.
Fan-made patches for Dark Spore often focus on resolving compatibility issues with modern operating systems, as the game was originally designed for older versions of Windows. For instance, community developers have created unofficial updates that allow the game to run smoothly on Windows 10 and 11, bypassing errors that prevent it from launching or cause crashes during gameplay. These patches typically involve modifying the game’s executable files or creating wrapper scripts that emulate the necessary environment for the game to function. Players can usually find these fixes on forums, GitHub repositories, or dedicated modding sites, often accompanied by detailed installation instructions to ensure accessibility for less tech-savvy users.
Beyond technical fixes, community patches also aim to enhance the gameplay experience. Some fan-made updates introduce quality-of-life improvements, such as rebalancing gameplay mechanics, adding new content, or improving the user interface. For example, certain mods expand the game’s creature editor, allowing players to create more diverse and complex organisms. Others address long-standing bugs or glitches that were never officially patched, ensuring a smoother and more enjoyable experience. These enhancements not only breathe new life into the game but also demonstrate the community’s commitment to refining and expanding its potential.
However, it’s important to approach fan-made patches with caution. While many are well-intentioned and thoroughly tested, not all are created equal. Players should verify the credibility of the source and read user reviews or comments before downloading and installing any mods. Additionally, backing up the original game files is crucial, as some patches may inadvertently cause issues or conflicts. Forums and Discord communities dedicated to Dark Spore often provide recommendations and support, helping players navigate the world of community fixes safely.
In conclusion, fan-made patches play a vital role in keeping Dark Spore playable and enjoyable in the absence of official support. They not only address technical limitations but also enrich the gameplay experience, ensuring that the game remains relevant for both longtime fans and newcomers. By leveraging the collective skills and passion of the community, these patches serve as a powerful example of how players can take matters into their own hands to preserve the games they love. For those looking to revisit or discover Dark Spore, exploring these community fixes is a practical and rewarding step toward maximizing their experience.
Bacillus Anthracis Spores: Understanding Their Role in Anthrax Infections
You may want to see also
Frequently asked questions
No, Darkspore cannot be played as of 2023 because its servers were shut down in March 2016, making the game unplayable due to its reliance on online authentication.
Unfortunately, there is no official way to play Darkspore offline. The game required a constant internet connection to function, even for single-player modes.
While there have been discussions and attempts by fans to revive Darkspore, no successful projects have restored the game to a fully playable state as of now.
No, Darkspore is no longer available for purchase or download on any official platforms, including Steam, due to its discontinuation.
As of now, there are no official announcements or plans from Maxis or EA to re-release Darkspore. The game remains defunct, and its future is uncertain.